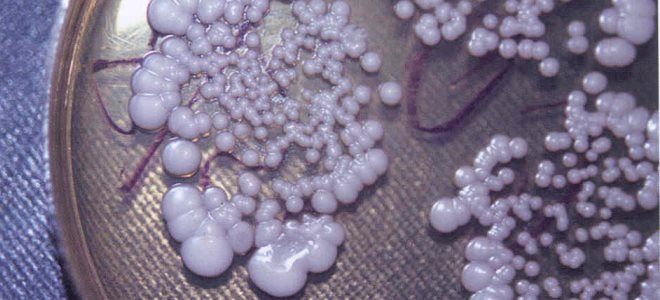
выделения при молочнице выделения при молочнице

Молочница, или вагинальный кандидоз, — распространенное заболевание, затрагивающее женщин в разные периоды жизни. Симптомы могут проявляться неожиданно и вызывать дискомфорт, поэтому важно уметь их распознавать. В статье рассмотрим основные симптомы, причины кандидоза и его влияние на здоровье, включая проявления в кишечнике, на коже и в полости рта. Понимание этих аспектов поможет женщинам своевременно обратиться за медицинской помощью и предотвратить осложнения.
Молочница у женщин – причины
Молочница — это грибковое заболевание, вызванное микроорганизмами из рода Кандида. В процессе своей жизнедеятельности они выделяют белое вещество, что и дало болезни ее народное название. Следует отметить, что этот грибок в небольших количествах присутствует в организме каждого человека, но его активизация происходит при возникновении определенных благоприятных условий.
Молочница у женщин может развиваться по следующим причинам:
- ношение тесного нижнего белья из синтетических материалов (Кандида часто поражает половые органы);
- наличие сахарного диабета;
- беременность;
- прием антибиотиков широкого спектра;
- длительное использование оральных контрацептивов;
- применение стероидных препаратов;
- использование внутриматочных средств контрацепции (диафрагм, спиралей);
- ослабление иммунной системы.
Молочница, или кандидоз, является распространенным заболеванием, вызываемым грибами рода Candida. Эксперты подчеркивают, что ключевыми симптомами этого недуга являются зуд и жжение в области влагалища, а также выделения, имеющие творожистую консистенцию и белый цвет. Женщины могут также испытывать дискомфорт во время полового акта и при мочеиспускании. Важно отметить, что симптомы могут варьироваться в зависимости от индивидуальных особенностей организма. Специалисты рекомендуют не игнорировать эти проявления и обратиться к врачу для подтверждения диагноза и назначения адекватного лечения. Раннее вмешательство поможет избежать осложнений и улучшить качество жизни.
https://youtube.com/watch?v=fd8g1Te51xU
Где бывает молочница?
Молочница у женщин чаще всего проявляется в области влагалища и вульвы. Это связано с тем, что именно здесь наблюдается наибольшее скопление грибка в организме. Как выглядит молочница у женщин в интимной зоне, известно практически каждой даме.
Тем не менее, стоит подчеркнуть, что при активном размножении грибка он может затрагивать и другие части тела:
- ротовую полость;
- слизистую кишечника;
- кожные участки (особенно в складках).
| Симптом | Описание | Примечания |
|---|---|---|
| Зуд и жжение | Интенсивный зуд в области влагалища и наружных половых органов, усиливающийся вечером, после душа или полового акта. Ощущение жжения, особенно при мочеиспускании. | Один из наиболее характерных и ранних симптомов. Может быть постоянным или приступообразным. |
| Творожистые выделения | Густые, белые или желтоватые выделения, напоминающие творог или хлопья. Могут иметь кислый запах, но часто без запаха. | Количество выделений может варьироваться от скудных до обильных. Не путать с обычными физиологическими выделениями. |
| Покраснение и отек | Покраснение и отек слизистой оболочки влагалища и больших половых губ. Кожа может быть раздраженной и чувствительной. | Визуально заметные изменения, часто сопровождающиеся болезненностью при прикосновении. |
| Боль при половом акте | Дискомфорт, жжение или боль во время полового акта (диспареуния) из-за воспаления и раздражения слизистой. | Может быть одним из первых признаков, особенно при хроническом течении. |
| Боль при мочеиспускании | Жжение или боль при мочеиспускании (дизурия), вызванная раздражением уретры из-за распространения инфекции. | Часто путают с циститом, но при молочнице обычно нет других симптомов цистита (частые позывы, ощущение неполного опорожнения). |
| Сыпь или трещины | В некоторых случаях могут появляться мелкие пузырьки, эрозии или трещины на слизистой оболочке влагалища и наружных половых органов. | Редкий, но возможный симптом, указывающий на более выраженное воспаление. |
| Неприятный запах | Хотя обычно выделения при молочнице не имеют сильного запаха, в некоторых случаях может присутствовать легкий кислый или дрожжевой запах. | Отсутствие сильного “рыбного” запаха, характерного для бактериального вагиноза, помогает дифференцировать эти состояния. |
Интересные факты
Вот несколько интересных фактов о молочнице (кандидозе) у женщин:
-
Причины и триггеры: Молочница вызывается грибком Candida, который обычно присутствует в небольших количествах в организме. Однако определенные факторы, такие как стресс, гормональные изменения, антибиотики и ослабленный иммунитет, могут привести к его избыточному росту, что вызывает симптомы кандидоза.
-
Симптомы: Основные симптомы молочницы включают зуд и жжение в области влагалища, белые творожистые выделения, а также болезненные ощущения при половом акте и мочеиспускании. Эти симптомы могут быть схожи с другими инфекциями, поэтому важно обратиться к врачу для точной диагностики.
-
Профилактика: Для предотвращения молочницы рекомендуется соблюдать гигиену, носить свободное и дышащее нижнее белье, избегать избыточного потребления сахара и углеводов, а также поддерживать баланс микрофлоры с помощью пробиотиков.
https://youtube.com/watch?v=6YscvCl77uI
Признаки молочницы
Заболевание чаще всего возникает на фоне общего хорошего состояния и нормального самочувствия. Первые симптомы молочницы у женщин проявляются неожиданно: начинается зуд, раздражение и покраснение в пораженной области. Обычно это влагалище. Вскоре появляются беловатые выделения, которые являются результатом активности грибка.
Жжение усиливается из-за сильного раздражения слизистой оболочки и становится невыносимым. С течением времени объем выделений увеличивается. Следует отметить, что симптомы часто зависят от места заражения и локализации воспалительного процесса. Прогрессирующая молочница у женщин, симптомы которой со временем могут ослабевать, может перейти в хроническую стадию.
Вагинальный кандидоз
Влагалищные выделения при молочнице являются одним из основных признаков этого заболевания. Они всегда сопровождаются интенсивным зудом, дискомфортом и жжением в области гениталий. В начале заболевания объем выделений небольшой: они имеют белый цвет, жидкую консистенцию и могут содержать небольшие белые сгустки. С увеличением колонии грибка выделения меняют свои характеристики: становятся более густыми, комковатыми и напоминают творожистую массу.
Среди других возможных симптомов, которые могут сопровождать влагалищную молочницу, врачи выделяют следующие:
- легкое повышение температуры тела (не всегда наблюдается);
- покраснение вульвы;
- отечность влагалища;
- появление неприятного кислого запаха выделений.
Кандидоз во рту – симптомы
Кандидоз горла, симптомы которого менее выражены по сравнению с поражением влагалища, часто возникает в результате орального секса. В редких случаях инфекция в ротовой полости может быть вызвана другими источниками в организме. У детей данная форма кандидоза чаще всего возникает из-за инфицирования при прохождении через зараженные родовые пути матери, что делает ее распространенной среди новорожденных.
Могут поражаться:
- ротовая полость;
- глотка;
- щеки;
- твердое нёбо;
- язык.
Сначала родители могут заметить у малыша небольшие белые точечные налеты на языке и щеках. На ранних стадиях молочницу во рту у грудных детей часто принимают за остатки молока, которое остается после кормления. Однако со временем появляются пленки, напоминающие свернувшееся молоко. Налет легко удаляется при помощи шпателя, под ним обнаруживается ярко-красная поверхность, которая может кровоточить. Поражения обычно безболезненны, и ребенок выглядит здоровым.
Кандидоз кишечника
При анализе основных признаков молочницы у женщин важно отметить, что грибковое поражение кишечника встречается довольно редко. Клинические проявления зависят от типа заболевания:
- Неинвазивный кандидоз – на ранних стадиях болезнь может протекать без явных симптомов, но со временем возникают следующие проявления:
- умеренная интоксикация;
- вздутие живота;
- постоянный дискомфорт;
- нормальный стул чередуется с поносом;
- аллергические реакции на коже;
- спастические боли в нижней части живота;
- зуд в области ануса.
- Инвазивный кандидоз кишечника – для этой формы характерны следующие симптомы:
- болезненные ощущения при дефекации;
- наличие крови и слизи в кале;
- возможные желудочные и кишечные кровотечения;
- длительная субфебрильная температура;
- частая рвота;
- крапивница;
- мокнущий дерматит;
- потеря веса.
Следует выделить ряд симптомов, которые возникают в результате интоксикации организма и снижения его защитных функций:
- постоянная усталость;
- бессонница;
- повышенная раздражительность;
- депрессивные состояния;
- тревожность;
- резкие изменения настроения.
Кандидоз кожи
Кожный кандидоз, проявления которого не отличаются высокой интенсивностью, встречается довольно редко. Грибковая инфекция чаще всего затрагивает кожные складки. Данная форма заболевания нередко называется врачами кандидозным интертриго.
У взрослых данная патология в основном поражает крупные кожные складки:
- ягодичные;
- паховые;
- подмышечные;
- в области промежности;
- шейные;
- на животе (особенно у людей с избыточным весом).
У женщин в этой форме заболевания может наблюдаться поражение вульвы и кожи под молочными железами. В начале в глубине складки появляется белая полоска мацерированного рогового слоя кожи, в которой образуются эрозивные участки и трещины. Образовавшаяся эрозия имеет неровные края, окруженные белой каймой, отделяющей её от здоровой кожи. Поражения кожи сопровождаются выраженным зудом.
Может ли молочница быть признаком беременности?
Часто первые проявления молочницы женщины замечают на ранних сроках беременности. Однако в этот период они могут и не подозревать о своем интересном положении. Не стоит рассматривать симптомы молочницы как однозначный признак беременности. Увеличение активности грибка на ранних сроках связано с естественным снижением иммунной защиты организма, что может происходить и у женщин, не находящихся в положении, например, из-за различных заболеваний.
Молочница – чем лечить у женщин?
Для многих женщин диагноз “молочница” становится источником тревоги: как действовать, чем лечить, какие лекарства применять – эти вопросы волнуют немногих. Врачи подчеркивают, что лечение данной болезни требует комплексного подхода.
Терапия включает в себя следующие направления:
- Устранение предрасполагающих факторов.
- Соблюдение диеты (снижение потребления углеводов).
- Отказ от вредных привычек.
- Местное медикаментозное лечение.
Основными средствами для борьбы с кандидозом являются противогрибковые препараты, которые представлены в различных формах:
- Бутоконазол (крем);
- Кетоконазол (суппозитории);
- Флуконазол (таблетки);
- Клотримазол (влагалищные таблетки);
- Миконазол (вагинальные суппозитории);
- Нистатин (вагинальные таблетки).
https://youtube.com/watch?v=Qlq-g3i4xig
Профилактика молочницы у женщин
Профилактика молочницы, или кандидоза, у женщин является важным аспектом поддержания здоровья и предотвращения рецидивов этого неприятного заболевания. Существует несколько ключевых рекомендаций, которые помогут снизить риск развития молочницы.
1. Соблюдение личной гигиены. Регулярное соблюдение правил личной гигиены – это основа профилактики молочницы. Женщинам рекомендуется ежедневно мыть интимные зоны, используя мягкие, неагрессивные средства, которые не нарушают естественный баланс микрофлоры. Избегайте использования ароматизированных мыл и гелей, так как они могут вызвать раздражение и дисбаланс.
2. Правильное ношение нижнего белья. Выбор нижнего белья также играет важную роль в профилактике кандидоза. Рекомендуется носить хлопковое белье, которое позволяет коже дышать и не создает парниковый эффект. Синтетические ткани могут способствовать повышенной влажности и развитию грибков. Также стоит избегать слишком тесного белья и леггинсов.
3. Здоровое питание. Питание напрямую влияет на иммунную систему и состояние микрофлоры. Включение в рацион продуктов, богатых пробиотиками (например, йогурты, кефир), может помочь поддерживать баланс полезных бактерий. Ограничение потребления сахара и углеводов также важно, так как дрожжи, вызывающие молочницу, питаются сахаром.
4. Укрепление иммунной системы. Поддержание иммунной системы в хорошем состоянии – еще один важный аспект профилактики. Регулярные физические нагрузки, достаточный сон и управление стрессом способствуют укреплению иммунитета. Витамины и минералы, такие как витамин C, цинк и магний, также играют важную роль в поддержании здоровья.
5. Избегание антибиотиков без необходимости. Антибиотики могут нарушить баланс микрофлоры, что увеличивает риск развития молочницы. Если есть необходимость в их применении, стоит обсудить с врачом возможность использования пробиотиков для восстановления микрофлоры после курса лечения.
6. Регулярные медицинские осмотры. Регулярные визиты к гинекологу помогут своевременно выявить и устранить возможные проблемы. Важно сообщать врачу о любых изменениях в состоянии здоровья, включая симптомы, которые могут указывать на молочницу.
Соблюдение этих рекомендаций поможет значительно снизить риск развития молочницы и поддерживать здоровье женской репродуктивной системы. Однако, если симптомы кандидоза все же возникли, важно обратиться к врачу для получения квалифицированной помощи и назначения адекватного лечения.
Вопрос-ответ
Какие основные симптомы молочницы у женщин?
Основные симптомы молочницы включают зуд и жжение в области влагалища, белые творожистые выделения, а также дискомфорт во время полового акта и при мочеиспускании. Эти проявления могут варьироваться по интенсивности и продолжительности.
Каковы причины возникновения кандидоза у женщин?
Кандидоз может возникать по различным причинам, включая нарушение баланса микрофлоры влагалища, ослабление иммунной системы, прием антибиотиков, гормональные изменения, а также стресс и неправильное питание. Все эти факторы могут способствовать избыточному размножению грибка Candida.
Как лечить молочницу и какие меры профилактики существуют?
Лечение молочницы обычно включает противогрибковые препараты, которые могут быть назначены врачом. Профилактика включает поддержание нормального уровня микрофлоры, соблюдение гигиенических норм, избегание синтетического нижнего белья и контроль за уровнем сахара в крови, особенно у женщин с диабетом.
Советы
СОВЕТ №1
Обратите внимание на симптомы: зуд, жжение и необычные выделения могут быть первыми признаками молочницы. Если вы заметили эти симптомы, не откладывайте визит к врачу для диагностики и назначения лечения.
СОВЕТ №2
Следите за своим рационом: употребление большого количества сахара и углеводов может способствовать развитию кандидоза. Постарайтесь ограничить сладости и включить в рацион больше овощей и пробиотиков, чтобы поддерживать баланс микрофлоры.
СОВЕТ №3
Избегайте самодиагностики и самолечения: многие женщины склонны пытаться лечить молочницу самостоятельно, что может привести к ухудшению состояния. Обратитесь к специалисту для получения точного диагноза и эффективного лечения.
СОВЕТ №4
Поддерживайте гигиену: носите хлопковое белье и избегайте синтетических тканей, которые могут создавать благоприятную среду для размножения грибков. Регулярная гигиена поможет снизить риск возникновения молочницы.